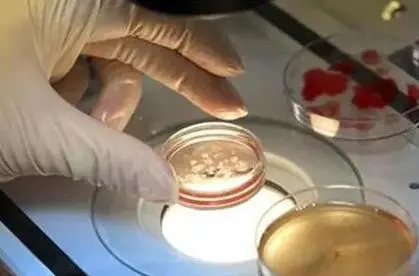
42岁做一代试管还是三代试管

42岁想做试管是选择一代试管还是三代试管
试管婴儿是一种辅助的生殖医疗技术,一共有一代二代三代,而在众多试管技术中,一代试管和三代试管因其各自的特点和优势,成为了不少高龄夫妇关注的焦点。那么,对于42岁的夫妇来说,究竟应该选择一代试管还是三代试管呢?
什么是一代试管和三代试管
一代试管,即体外受精-胚胎移植(IVF-ET),是最早也是最常见的试管婴儿技术。它通过将精子和卵子在体外结合,形成胚胎后再移植到母体子宫内进行妊娠。而三代试管,则是指基于一代试管的基础上,增加了胚胎遗传学诊断(PGD)或胚胎遗传学筛查(PGS)技术,可以对胚胎进行遗传学检测,筛选出染色体异常或携带特定遗传疾病的胚胎,从而提高试管婴儿的成功率和质量。
42岁做一代试管还是三代试管
对于42岁的高龄女性来说,选择三代试管婴儿可能更为合适。随着年龄的增长,女性的卵巢储备功能逐渐下降,卵子发育异常的风险增加。如果只选择一代试管婴儿,难以确保取出的卵子质量。即使试管婴儿成功,胎儿畸形或流产的风险也会相对较高。而三代试管婴儿在移植前会进行胚胎筛查,剔除可能发育异常的胚胎,从而确保胎儿的健康。因此,对于高龄女性来说,三代试管婴儿可能是一个更为理想的选择。
成功率:随着年龄的增长,女性的卵巢功能逐渐下降,卵子的质量和数量都会受到影响。因此,42岁的女性进行试管婴儿的成功率相对较低。三代试管通过遗传学筛查,可以筛选出更为优质的胚胎进行移植,从而在一定程度上提高成功率。
风险:虽然三代试管可以提高成功率,但它也涉及到更为复杂的操作和技术,因此存在一定的风险。例如,PGD/PGS技术可能导致胚胎损伤或误判,从而影响到试管婴儿的成功和质量。而一代试管虽然操作简单,但成功率相对较低,可能需要多次尝试。
广东适合高龄做试管的医院
1. 中山大学附属第一医院生殖医学中心
中山大学附属第一医院生殖医学中心是广东省最早成立的生殖医学中心之一,拥有丰富的临床经验和先进的医疗设备。该中心拥有一支专业的医疗团队,致力于高龄夫妇的试管婴儿治疗,取得了良好的治疗效果。
2. 广东省妇幼保健院生殖健康与不孕症科
广东省妇幼保健院生殖健康与不孕症科是广东省内知名的生殖健康医疗机构。该科室拥有国内先进的试管婴儿技术,针对高龄夫妇的生殖问题,提供个性化的治疗方案,成功帮助许多高龄夫妇实现了生育梦想。
3. 广州市妇女儿童医疗中心生殖医学科
广州市妇女儿童医疗中心生殖医学科是一家集医疗、教学、科研为一体的现代化生殖医学机构。该科室注重高龄夫妇的生殖健康,拥有先进的试管婴儿技术和丰富的临床经验,为高龄夫妇提供安全、有效的治疗服务。
4. 深圳市妇幼保健院生殖医学中心
深圳市妇幼保健院生殖医学中心是深圳市重点发展的生殖医学机构之一。该中心致力于高龄夫妇的试管婴儿治疗,拥有国内领先的试管婴儿技术和设备,为高龄夫妇提供全方位、个性化的生殖健康服务。
基于网友自述病情所发表的言论仅供参考,不能作为诊断和治疗的直接依据。
